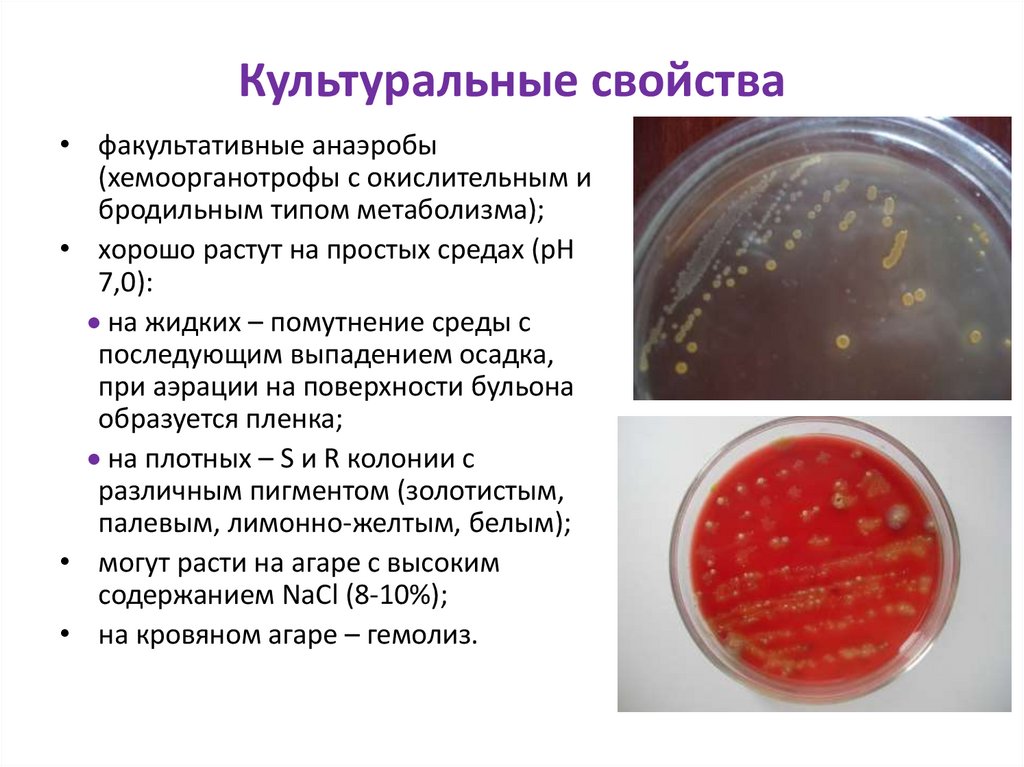
Культуральные свойства
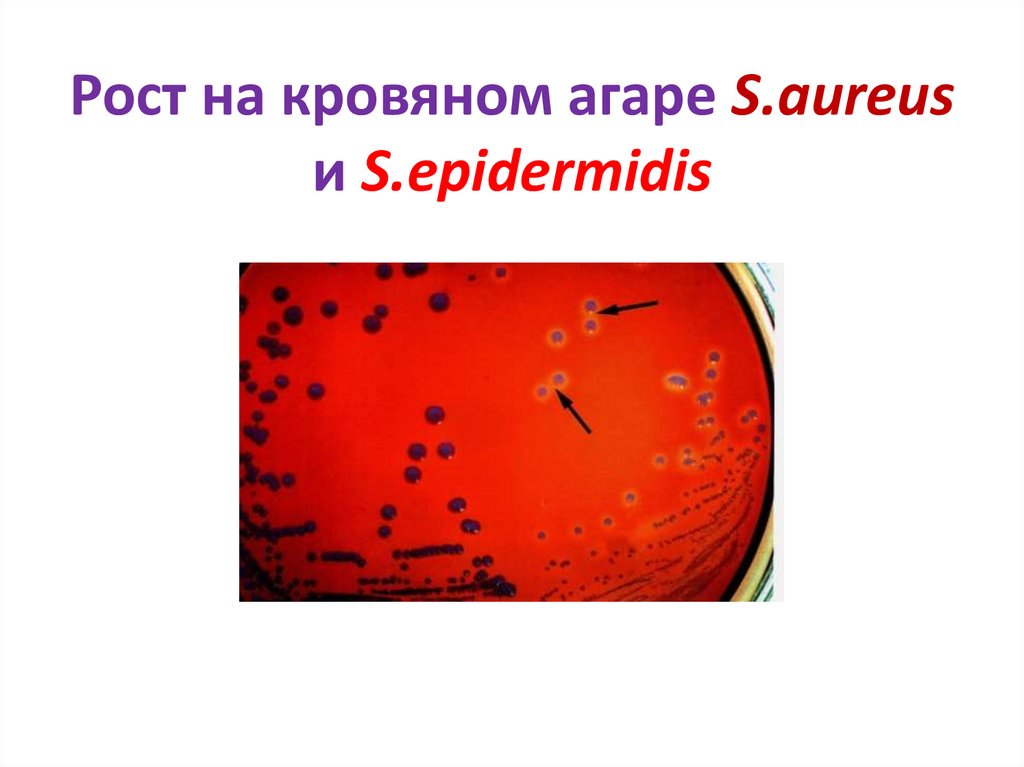
Рост на кровяном агаре S.aureus и S.epidermidis
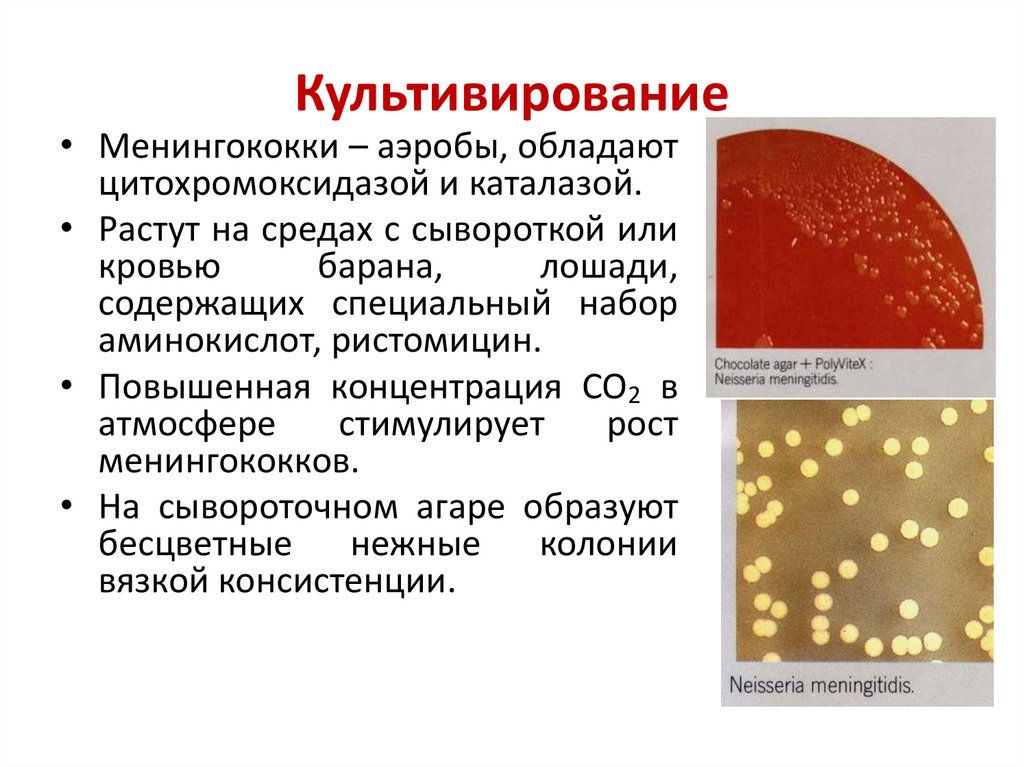
Культивирование
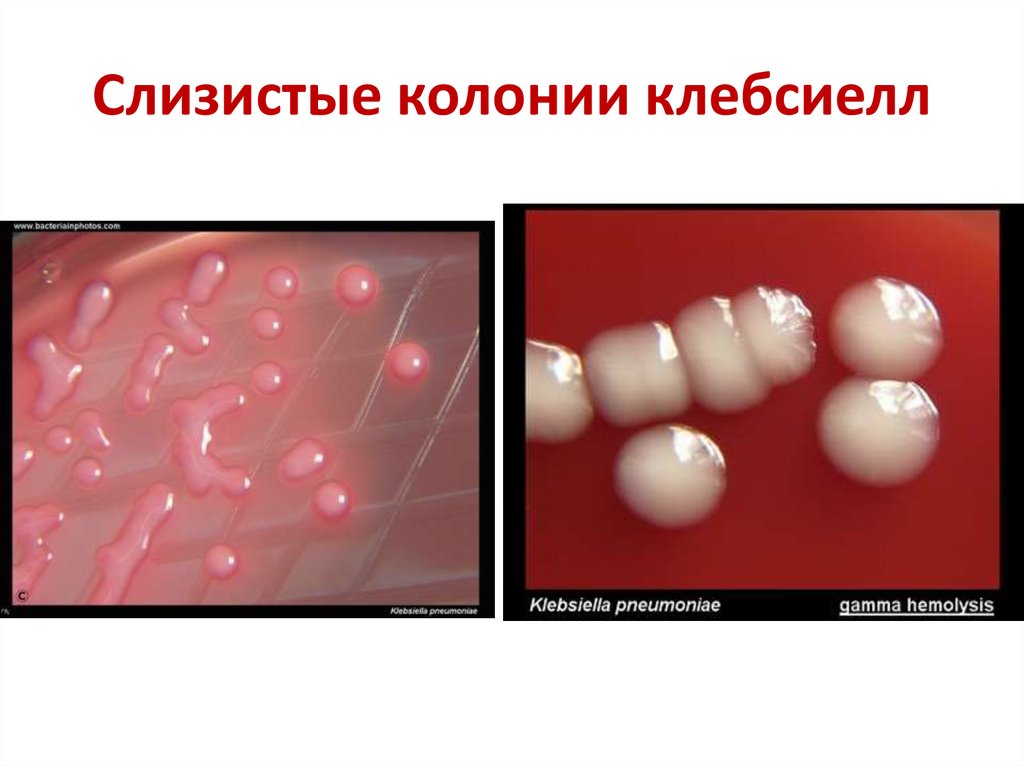
Слизистые колонии клебсиелл
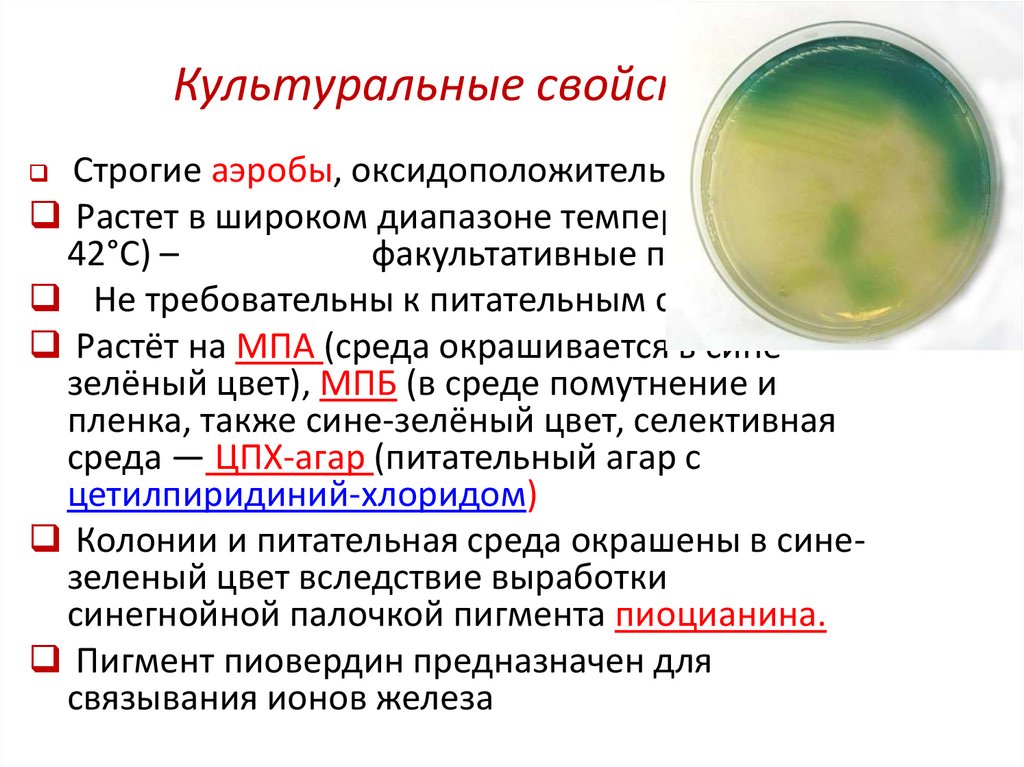
Культуральные свойства
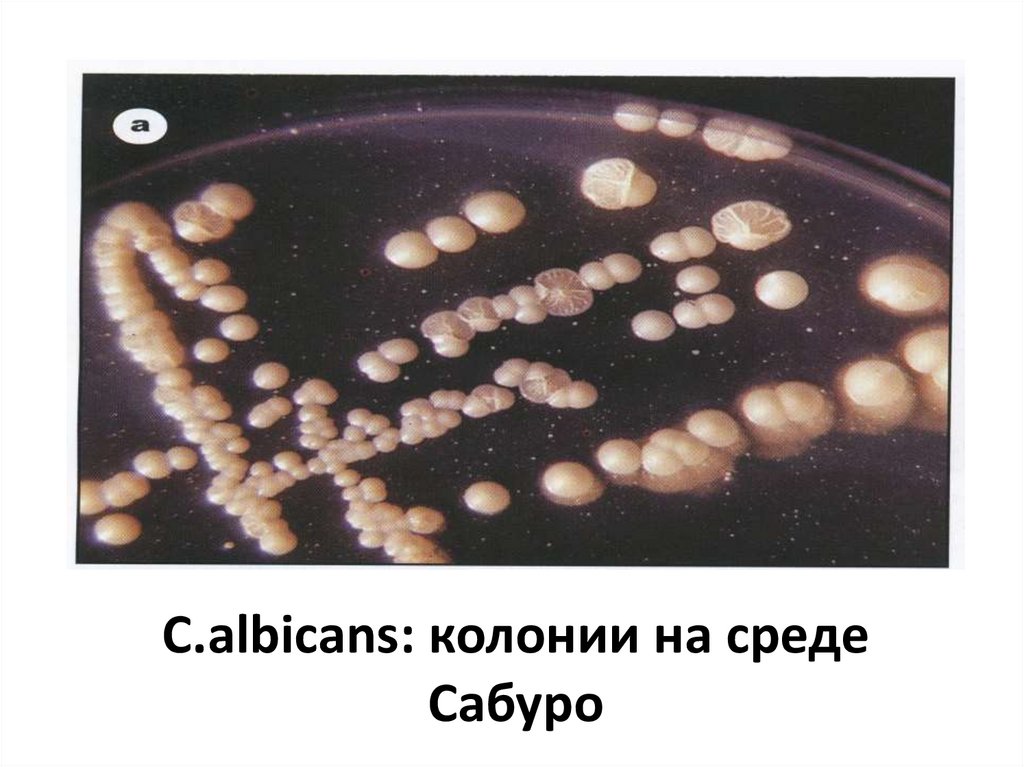
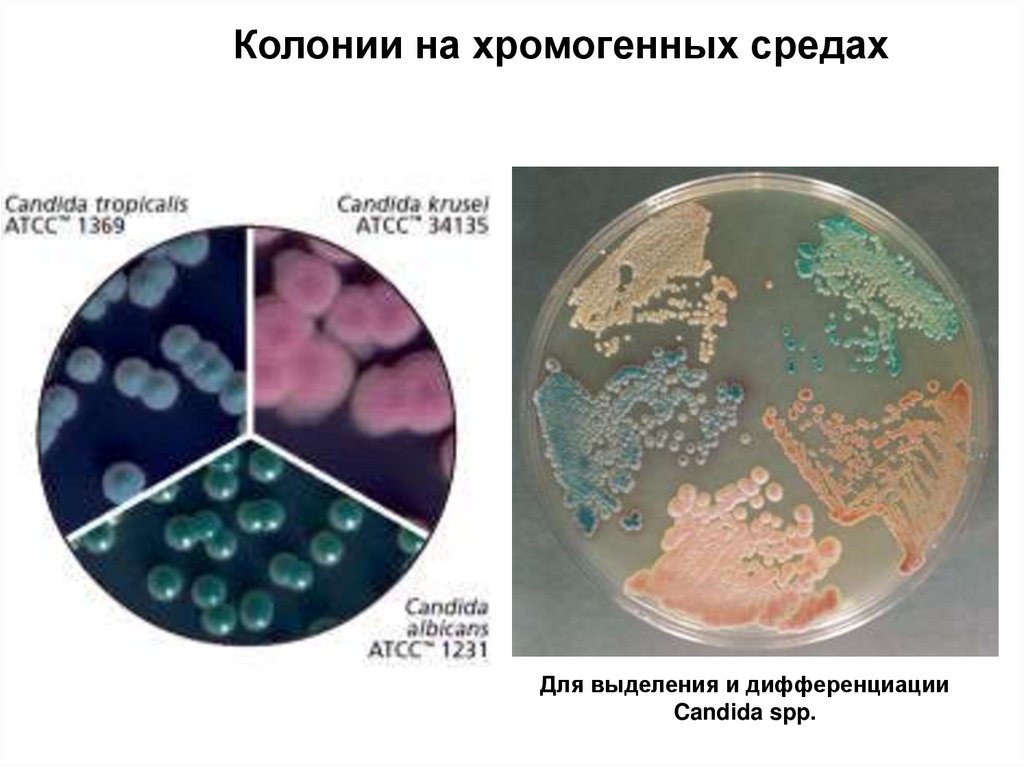
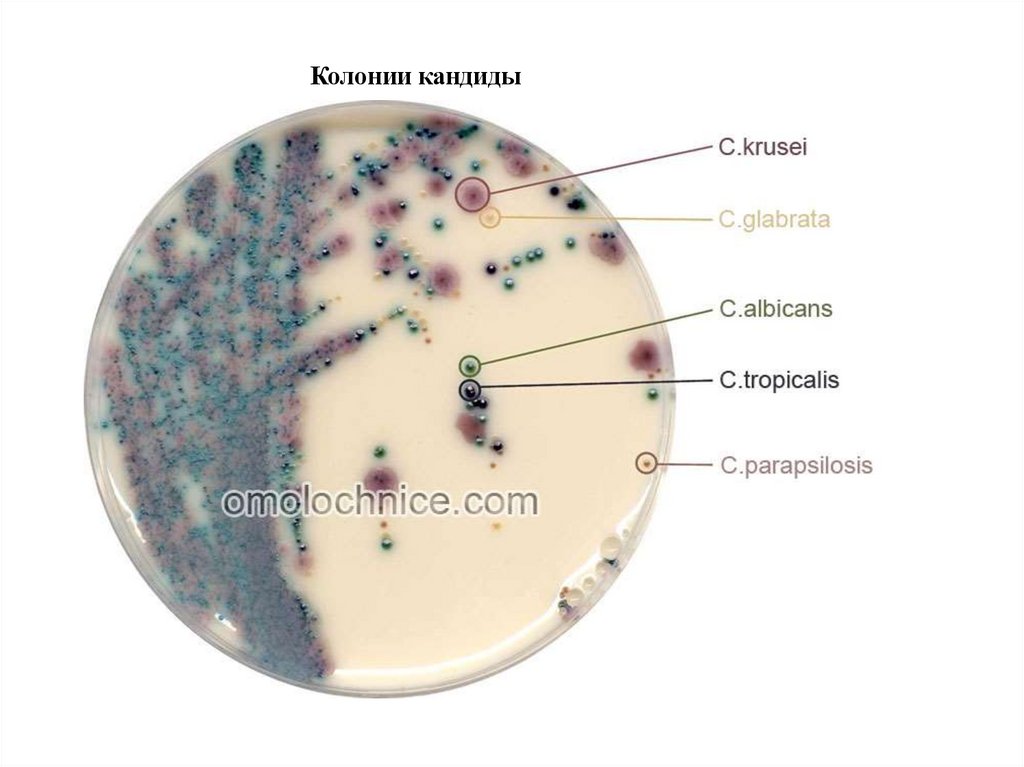
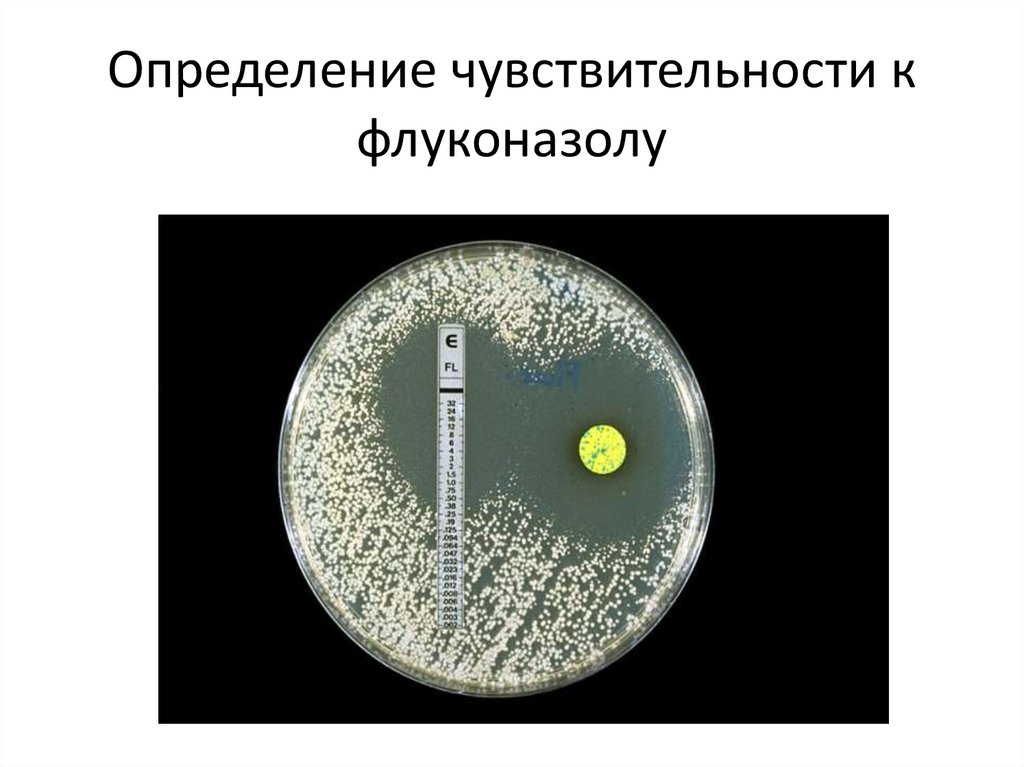

Similar presentations:
лек_Условно_патогенные_микроргнаизмы (2)
1. Лекция Условно-патогенные микробы
Содержание учебного материала:• Стафилококки;
• Стрептококки;
• Гонококки;
• Клебсиеллы;
• Протей;
• Псевдомонады;
• Неспорообразующие анаэробы;
• Дрожжеподобные грибы.
2. ПАТОГЕННЫЕ КОККИ
• Патогенные и условно-патогенные.• Строгие
анаэробы
(пептококки,
пептострептококки,
вейлонеллы),
факультативные анаэробы и аэробы
(стрептококки, стафилококки, нейссерии).
• Гнойно-воспалительные болезни различной
локализации и тяжести.
3. ОБЩАЯ ХАРАКТЕРИСТИКА ПАТОГЕННЫХ КОККОВ
ВОЗБУДИТЕЛЬСТАФИЛОКОККИ
ПАТОГЕННОСТЬ
ГРАМ
ТОКСИН
ЧЕЛОВЕК,
ЖИВОТНЫЕ
Г+
ЭКЗО
ЧЕЛОВЕК
Г–
ЭНДО
СТРЕПТОКОККИ
МЕНИНГОКОККИ
ГОНОКОККИ
РАСПРОСТРАНЕННОСТЬ
ФЕРМЕНТЫ
РЕЗИСТЕНТНОСТЬ
ТРЕБОВАТЕЛЬНОСТЬ К ПИТАТЕЛЬНЫМ
СРЕДАМ
4.
Патогенныекокки
Грамположительные
Грамотрицательные
5. Грамположительные кокки
• Стафилококки• Стрептококки
6. Таксономия
• Phylum BXIII. Firmicutes• Class III. "Bacilli"
• Order I. Bacillales
• Family V. "Staphylococcaceae"
• Genus I. Staphylococcus
• Species. S.aureus, S.epidermidis,
S.saprophyticus
7. Морфология
• округлые клетки диаметром 0,5-1 мкм;• «гроздья винограда»
• плазмиды – синтез коагулазы, гемолитических
токсинов, фибринолизина, пигментов,
устойчивости к антибиотикам;
• спор не образуют, жгутиков не имеют;
• могут образовывать капсулу, чаще
полисахаридной природы.
• могут образовывать L-формы.
8. Тинкториальные свойства
• Грамположительны9. Культуральные свойства
• факультативные анаэробы(хемоорганотрофы с окислительным и
бродильным типом метаболизма);
• хорошо растут на простых средах (рН
7,0):
на жидких – помутнение среды с
последующим выпадением осадка,
при аэрации на поверхности бульона
образуется пленка;
на плотных – S и R колонии с
различным пигментом (золотистым,
палевым, лимонно-желтым, белым);
• могут расти на агаре с высоким
содержанием NaCl (8-10%);
• на кровяном агаре – гемолиз.
10. Рост на кровяном агаре S.aureus и S.epidermidis
11. Ферментативные свойства
• биохимически активны: ферментируют с выделением кислотыглицерин, мальтозу, сахарозу, маннит, восстанавливают нитраты в
нитриты, продуцируют уреазу, фосфатазу, аргиназу.
• Глюкозу ферментируют как в аэробных и анаэробных условиях.
• Выделяют сероводород и аммиак.
• Оксидазоотрицательны.
• Стафилококки делятся на каталазоположительные (S.aureus) и
каталазоотрицательные (S. epidermidis, S. saprophyticus).
• S. epidermidis не сбраживает маннита.
• S. saprophyticus не сбраживает маннозу, не продуцирует фосфатазу.
Глюкоза Лактоза Маннит Сахароза
К
К
К
К
H2 S
Индол
+
–
12. Патогенность
• адгезия: тейхоевые кислоты, капсульные полисахариды;• капсула: индукция цитокинов → возникновение очагов
воспаления → образование абсцессов; подавление активности
фагоцитов;
• факторы угнетающие фагоцитоз (белок А, пептидогликан,
тейхоевые кислоты);
• около 30 ферментов агрессии: плазмокоагулаза, ДНКаза,
лейкоцидины, лецитовителлаза, фосфатаза, бактериоцины,
гемолизины α, β, γ, δ, фибринолизин, и др.
• каталаза, каратиноидные пигменты – защита от оксидантов;
• устойчивость к антибиотикам: R-плазмиды, β-лактамазы;
• токсины.
13. Токсины стафилококков
• эксфолиативные токсины А и В – суперантигены,вызывают слущивание эпидермиса, отслойку
рогового слоя и развитие синдрома ошпаренной
кожи;
• энтеротоксины А, В, С, С1 С2, D, Е
–
термостабильные низкомолекулярные белки,
суперантигены;
• токсин синдрома токсического шока (раннее
энтеротоксин F) - экзотоксин, характеризующийся
слабой
гемолитической
и
высокой
протеолитической активностью;
• β–токсин – цитотоксическое действие;
• γ–токсин лизирует эритроциты;
• δ–токсин
обладает
широким
спектром
цитотоксической активности.
14. Антигенные свойства
• около 30 АГ: белки, полисахариды и тейхоевые кислоты.• выделяют 6 эковаров стафилококков (А, В, С, D, E, F). Эковар А
вызывает заболевания у человека, а остальные – у животных.
Внутри эковара А выделяют 46 фаговаров.
• Чувствительность к бактериофагам является стабильной
генетической
характеристикой,
что
обусловлено
поверхностными рецепторами. Многие штаммы стафилококков
являются лизогенными (образование некоторых токсинов
происходит с участием профага).
• В составе клеточной стенки стафилококка содержится протеин
А, который может прочно связываться с Fc-фрагментом
молекулы Ig, (коагглютинация).
• Большинство
внеклеточных
веществ,
продуцируемых
стафилококками, также обладают антигенной активностью.
15. Патогенез
• Источник стафилококковой инфекции – человек,животные (больные или носители).
• 20% людей не поддерживают носительства, 60% –
транзиторное
носительство,
20%
–
длительное
носительство,
(эпидемически
опасным
считается
присутствие более 10 млн. бактерий в 1 мл назального
секрета).
• Механизм передачи – респираторный, контактнобытовой, алиментарный.
• Восприимчивость людей всеобщая.
• Входные ворота – кожа, слизистые.
• Резистентность ↑ – локальная инфекция; ↓ –
генерализованная инфекция.
16. Клиническое разнообразие
• способностьстафилококка
вызывать
пиогенную инвазию кожи и ее придатков;
• проникать в кровь и индуцировать
пиогенные
(гнойно-деструктивные)
поражения внутренних органов;
• вызывать неспецифическую (септическую)
и специфические интоксикации.
17. Клиническое разнообразие
• Около 120 клинических формгнойно-воспалительные болезни
кожи и мягких тканей (фурункулы,
абсцессы, пиодермии и др.),
поражения глаз, уха, носоглотки,
урогенитального
тракта,
пищеварительной
системы
(интоксикации),
опорнодвигательного аппарата и других
органов.
• Острые кишечные заболевания и
менингиты
стафилококки
вызывают у новорожденных и
детей младшего возраста.
18.
• Наиболеепоражаемые
органы.
Практически все органы.
• Выведение возбудителя во внешнюю
среду осуществляется с мокротой, мочой,
испражнениями, гнойным отделяемым.
• Механизмы саногенеза: гуморальные и
клеточные
факторы
(антитоксины,
антимикробные антитела, фагоцитоз).
19. Микробиологическая диагностика
Материал: гнойное отделяемое, кровь, спинно-мозговая жидкость, слизьиз зева и носа, мокрота, испражнения, моча, рвотные массы,
промывные воды желудка, зараженные пищевые продукты.
+ ответ ориентировочный.
+ основной. Отнесение культуры к роду стафилококков
основывается на типичной морфологии и окраске клеток, их
взаимном расположении и анаэробной ферментации глюкозы. Для
видовой идентификации используют в основном биосинтез
плазмокоагулазы, лецитиназы, анаэробную ферментацию маннита
и глюкозы. В сомнительных случаях ставят тесты на ДНК-азу и αтоксин. Необходимо использование количественных методов
исследования.
–
исключение
–
энтероинфекция,
заражают
котят.
Дермонекротическую пробу проводят на кроликах.
+ при хронизации процесса (РНГА, РИФ, ИФА ).
– Тип ответа смешанный – ВТ.
20. Лечение и профилактика
антибиотики;
антитоксическая стафилококковая плазма или Ig,
нормальный донорский Ig;
адсорбированный стафилококковый анатоксин;
вакцина стафилококковая;
бактериофаг стафилококковый.
Профилактика
стафилококковых
инфекций
у
новорожденных:
иммунизация
рожениц
стафилококковым анатоксином, проведение анализа на
обсемененность материнского молока.
21. Стрептококки 11.10.24
22. Таксономия
• Family VI. Streptococcaceae• Genus I. Streptococcus
• Species. S.pyogenes, S.pneumonia,
S.agalactia, S.mutans, S.mitis, S.
salivarium
23. Классификация стрептококков
• По культуральным признакам.• По гемолитической активности:
α-гемолитические – дают частичный гемолиз
и зеленоватое окрашивание среды;
β-гемолитические – полностью
гемолизирующие стрептококки;
γ – не гемолитические - не вызывают
гемолиз.
Альфа и альфа1 стрептококки называют S. viridans
– зеленящие.
• Серологическая классификация Ребекки
Лэнсфильд (по группоспецифическим
полисахаридным АГ клеточной стенки): 20
серологических групп от А до V. Серовары – по
специфическим белковым АГ.
24.
Стрептококки группы А:S.pyogenes
S.pneumonia
25. Streptococcus pyogenes
26. Морфология
• мелкие (0,5-2 мкм) шаровидные клетки;• располагаются цепочками или попарно;
• спор не образуют, неподвижны;
• образуют капсулу, состоящую из гиалуроновой
кислоты;
• клеточная стенка содержит белки (М,- Т- и R),
углеводы и пептидогликаны;
• образуют L-формы.
27. Тинкториальные свойства
• грамположительные28. Культуральные свойства
• Стрептококки – факультативные анаэробы, растут насредах, обогащенных углеводами, кровью, сывороткой,
асцитической жидкостью;
• на плотных питательных средах образуют колонии трех
типов:
мукоидные – крупные блестящие вязкой консистенции,
напоминающие каплю воды (капсульные штаммы),
R – штаммы, имеющие М АГ,
S – невирулентные штаммы;
• на жидких средах – придонно-пристеночный рост в виде
крошковатого осадка.
29. Культуральные свойства
• по характеру роста накровяном агаре делятся на:
α-гемолитические –
зеленящие,
β-гемолитические,
дающие полный гемолиз,
негемолитические.
30. Ферментативные свойства
• S. pyogenesферментирует глюкозу,
мальтозу, лактозу, сахарозу, маннит с
образованием кислоты без газа.
• Расщепляет салицин, трегалозу.
• Протеолитической
активностью
не
обладает.
31. Антигенные свойства
• Полисахаридный АГ – «субстанция С» (поЛенсфилд) S.pyogenes – серогруппа А.
• Белковый АГ М – типовой (свыше 100 серотипов
серогруппы А).
• Перекрестные АГ: АТ к ним реагируют с
мышечными волокнами миокарда, тканью почки
и др. → иммунопатологические состояния.
• Капсула состоит из гиалуроновой кислоты
идентичной обнаруживаемой в соединительной
ткани человека (стрептококки не распознаются
как «чужие»).
32. Патогенность
• Адгезия – капсульные полисахариды, М- (адгезия к кератоцитам иподавление фагоцитоза) и F-белки (адгезия к эпителию
респираторного тракта и к клеткам Лангерганса кожи).
• Инвазия: гиалуронидаза, ДНКаза, РНК-аза, АТФ-аза и др.
• Стрептокиназа (фибринолизин) – растворение фибрина,
генерализация.
• О-стрептолизин разрушает мембраны клеток, лизосом,
кардиотоксичен, АГ – анти-О-стрептолизины.
• S-стрептолизин – разрушает мембраны.
• Кардиогепатический токсин вызывает поражения миокарда и
диафрагмы, образование гигантоклеточных гранулем в печени .
• Эритрогенины (термостабильный токсин А, токсин С) – нарушают
межклеточные
контакты,
пирогенность,
действуют
иммуноопосредовано вызывая образование ярко-красных
кожных высыпаний.
33. Патогенез
• Источник инфекции – больной, реконвалесцент, носитель.• Механизмы передачи – аспирационный, контактный, реже
алиментарный.
• Пути передачи – воздушно-капельный, прямой и непрямой
контакт, пищевой.
• Входные ворота – миндалины, слизистые оболочки верхних
дыхательных путей, поврежденная кожа, у новорожденных
– пупочная ранка.
• ↑ резистентность –локальная инфекция, ↓ резистентность
–генерализация (лимфо- и гематогенно).
• Наиболее поражаемый орган – небные миндалины
(тонзилит), сердечная мышца, кожа, подкожная клетчатка
(рожа, скарлатина); почка (острый гломерулонефрит).
34. Клиническое многообразие
• S.pyogenes может вызывать у человека:• гнойно-воспалительные
процессы
(ангина,
абсцессы,
флегмоны,
гаймориты, фронтиты, лимфадениты,
циститы, пиелонефриты и др.),
• ненагноительные
воспалительные
процессы
(рожа,
стрептодермия,
импетиго,
скарлатина,
острая
ревматическая
инфекция
гломерулонефрит, эндокардит и др.),
• генерализованные формы инфекции –
токсический шок, сепсис.
35. Скарлатина
• Остроеинфекционное
заболевание,
характеризующееся
ангиной,
общей
интоксикацией,
появлением
точечных
высыпаний на шее и
груди
ярко-красного
цвета
(scarlatinum
–
красный цвет).
• Скарлатинозный
синдром – эритрогенный
токсин.
• Болеют дети от 1 года до
8 лет.
36. Рожа
• Острое флегмоноподобноевоспаление кожи.
• erysipelas (греч. – красная
кожа).
• Инфекция распространяется в
субэпителиальной ткани лица,
головы, нижних конечностей,
реже других частей тела.
37. Ревматизм, гломерулонефрит
• Механизмы патогенеза:перекрестные АГ стрептококка,
развитие гиперчувствительности
иммунокомплексного типа,
длительная персистенция L-форм стрептококков.
• ревматизму чаще предшествуют поражение
миндалин и глотки;
• гломерулонефриту
–
кожные
формы
стрептококковой инфекции.
38. Механизмы саногенеза
• Антитоксины,типоспецифические
Мантитела, иммунный фагоцитоз.
• После
перенесения
скарлатины
формируется
напряженный
антитоксический иммунитет.
39. Микробиологическая диагностика
Материал : гной, слизь из зева и носа, моча и др. Приподозрении на сепсис – кровь.
1. + ориентировочный.
2. + основной. Материал засевают на кровяной агар,
колонии характеризуют по характеру гемолиза,
идентифицируют по антигенным свойствам в РП со
специфическими сыворотками. Для
дифференциации стрептококков группы А от
других β-гемолитических стрептококков
применяют тест чувствительности к бацитрацину
(чувствительны). РИФ, ИФА, ПЦР.
Специфичным является тест гидролиза
пирролидонил-бета нафтоламида (ПИРтест). S. pyogenes – единственный
стрептококк, дающий положительную
ПИР-реакцию.
40. Микробиологическая диагностика
3. +Вирулентность микроорганизмов определяютвнутрибрюшинным введением культуры
стрептококков кроликам.
4. + при хронических формах, для подтверждения
диагноза ревматизма. АТ к О-стрептолизину в
РСК или РП.
5. – тип иммунного ответа ВТ.
41. Лечение и профилактика
• Лечениеантибиотиками
( -лактамы,
макролиды).
• Стрептококковый бактериофаг.
• При скарлатине ослабленным детям вводят
иммуноглобулин.
• Профилактика неспецифическая.
42. Пневмококки (тема респираторные инфекции) Streptococcus pneumoniae
• Можетвызывать
пневмонии, бронхиты,
воспалительные
процессы ВДП и пазух
носа, среднего уха,
роговицы,
сепсис,
менингит, эндокардит,
артрит и т.д.
43. Морфология
• ланцетовидныедиплококки, короткие
цепочки;
• полисахаридная капсула;
• М-протеин иной
антигенной
специфичности, чем у
S.pyogenes;
• неподвижны, спор не
образуют.
44. Тинкториальные свойства
• Грамположительны45. Культивирование
• факультативные анаэробы;• на питательных средах теряют капсулу и
переходят из S- в R-форму;
• растут на кровяных и сывороточных средах;
• на кровяном агаре образуют мелкие, точечные
колонии, окруженные неполной зоной гемолиза
( -гемолиз);
• рост
на
питательных
средах
угнетается
оптохином.
46. Ферментативные свойства
• Расщепляют до кислоты, без газа глюкозу,мальтозу, галактозу и др.
• Оксидазу и каталазу не продуцирует.
47. Антигенная структура
• S.pneumoniae содержит:поверхностный
полисахаридный
капсульный АГ – «К-антиген»;
полисахаридный АГ клеточной стенки (Сполисахарид) – видоспецифический АГ;
М-протеин.
• По капсульному АГ – 90 сероваров.
48. Патогенность
• Адгезия – капсульные полисахариды, тейхоевыекислоты и М-белок;
• нейраминидаза;
• Цитотоксин (пневмолизин);
• гемолизины;
• ферменты: пептидаза, расщепляющая IgA,
гиалуронидаза,
способствующая
распространению пневмококка в тканях;
• агрессины, подавляющие фагоцитоз (капсула,
протеин М);
• мурамидаза (лизоцим), подавляющая многие
бактерии → колонизация.
49. Патогенез
Источник – больной, носитель.
Механизмы заражения – аспирационный, контактный.
Путь – воздушно-капельный, прямой контакт.
Входные ворота – слизистые ВДП.
Инфицирование слизистых респираторного тракта чаще
происходит при нарушении их целостности вирусами
(риновирусы, аденовирусы).
• Пневмококки вызывают бронхиты, пневмонию, реже
бактериемию, септицемию и менингит. Генерализованные
формы чаще встречаются у маленьких детей и пожилых
людей.
50. Иммунитет
• Иммунитет к пневмококковой инфекциитипоспецифический.
• Реализуется через АТ, фагоцитоз и
комплемента.
51. Микробиологическая диагностика
Материал: мокрота, смывы сбронхов, плевральная
жидкость.
1. + ориентировочный.
2. + основной. Количественный:
106
3. + биопроба с целью выделения
чистой культуры.
4. + РНИФ, ИФА.
5. –.
52. Лечение и профилактика
• Для лечения – антибиотики (β-лактамы,макролиды и др.).
• Пневмококки чувствительны ко многим
антибактериальным препаратам, включая
пенициллины.
• Вакцина разработана, но ее эффективность
и целесообразность применения не
бесспорны.
53. Стрептококки группы В
• S.agalactia – β-гемолитический стрептококк.• Отличие
от
S.pyogenes:
группоспецифический АГ.
• S.agalactia
колонизирует
слизистую
оболочку влагалища, выделяется от 10%
здоровых женщин, а при беременности –
до 25%.
• S.agalactia
наиболее
опасен
для
новорожденных
(заражаются
проходя
через инфицированный родовой канал).
• Может
вызывать
послеродовые
и
урогенитальные инфекции, маститы и
вагиниты у женщин, сепсис и менингиты у
новорожденных.
54. Стрептококки группы В
• по основным признакам не отличается отстрептококков серогруппы А
• Имеет подвариантные АГ, связанные с сиаловой
кислотой клеточной стенки, подразделяется на
подварианты: I, Ia, II и III.
Стрептококки групп С, F, G
• Как правило, β-гемолитические.
• Чувствительны к пенициллину.
• Представители нормальной микрофлоры кожи,
носоглотки, ЖКТ, генитального тракта.
• Основные свойства схожи со стрептококками групп А
и В.
• Встречаются
при
респираторных
инфекциях,
заболеваниях мочеполовой системы и некоторых
других.
55. Зеленящие стрептококки группы viridans, лишенные группоспецифического антигена
• Группа оральных стрептококков (S.mutans, S.salivarium, S.sanguis, S.oralis и др.).
• Отличаются
от
S.pyogenes
образованием
мембранотоксина
с
-гемолитической
активностью.
• Продуцируют
полисахаридный
адгезин,
способствующий
прилипанию
бактерий
к
сердечным клапанам и зубам.
• Могут вызывать стоматологические заболевания,
бактериемию, септический эндокардит.
56. Энтерококки
• Family Enterococcaceae• E.faecalis – 80-90%, E.faecium – 10-15%
• E.faecalis – условно-патогенный микроорганизм,
имеющий
санитарно-показательное
значение,
является обитателем кишечника человека.
• Вызывает раневую инфекцию, гнойно-воспалительные
заболевания желчно-выводящих путей, эндокардиты,
перитониты, уроинфекции (чаще всего в ассоциациях с
кишечной
палочкой,
протеем,
золотистым
стафилококком).
• E.faecalis может размножаться в пищевых продуктах и
вызывает пищевые токсикоинфекции.
• Устойчив к антибиотикам -лактамным 1 и 2
поколения.
57. Грамотрицательные кокки
• Основноезначение
–
Neisseria
(N.meningitidis и N.gonorrhoeae).
• Представители
родов
Bronhamella,
Moraxella могут вызывать у человека
воспалительные процессы.
• Acinetobacter
–
внутрибольничные
инфекции.
58. Нейссерии
59. Таксономия
• Family. Neisseriaceae• Genus. Neisseria
• Species. N.meningitidis,
N.gonorrhoeae
60. Менингококки Neisseria meningitidis
• Менингококковаяинфекция
–
острая
инфекционная болезнь,
характеризующаяся
поражением слизистой
оболочки
носоглотки,
оболочек
головного
мозга и септицемией;
антропоноз.
61. Морфология
• Мелкие (0,6-0,8 мкм)диплококки.
• Пара бобовидных клеток,
обращенных вогнутыми
поверхностями друг к
другу (кофейные зерна).
• Неподвижны, спор не
образуют,
грамотрицательны,
имеют пили, капсула
непостоянна.
62. Культивирование
• Менингококки – аэробы, обладаютцитохромоксидазой и каталазой.
• Растут на средах с сывороткой или
кровью
барана,
лошади,
содержащих специальный набор
аминокислот, ристомицин.
• Повышенная концентрация СО2 в
атмосфере
стимулирует
рост
менингококков.
• На сывороточном агаре образуют
бесцветные нежные колонии
вязкой консистенции.
63. Ферментативные свойства
• Менингококки расщепляют с образованиемкислоты глюкозу и мальтозу.
64. Антигенная структура
• По капсульным АГ – серогруппы А, В, С, D и др.• По АГ клеточной стенки – серовары (1, 2, 3 и т.д.).
• Во время эпидемических вспышек обычно
циркулируют менингококки группы А, они же
чаще встречаются при генерализованных формах
инфекции. В настоящее время чаще выделяются
менингококки серогрупп В и С.
65. Патогенность
Пили, белки наружной мембраны – адгезия;
капсульные полисахариды –резистентность к фагоцитозу;
нейраминидаза и гиалуронидаза – инвазия в ткани;
эндотоксин – ЛПС клеточной стенки, генерализация
инфекции, эндотоксический шок.
66. Патогенез
• Источник инфекции – больной или носитель (1520% здоровых носителей).• Механизм передачи – аспирационный, путь –
воздушно-капельный.
Встречается
преимущественно в зимне-весенний период.
• Входные ворота – слизистые ВДП.
• Динамика
распространения:
локальная
(назофарингит), генерализованная с прорывом
гематоэнцефалического барьера. Гематогенная
диссеминация.
• Наиболее поражаемые органы – оболочки мозга,
мозг
(головной,
спинной
–
менингит,
менингоэнцефалит), легкие (пневмонии).
67. Патогенез
• Ведущая роль в патогенезе тяжелых форм – инфекционнотоксический шок.• Причины
смерти:
острая
сердечно-сосудистая
недостаточность, отек головного мозга и легких, острая
почечная недостаточность.
• Летальность при менингококковой инфекции достигает
12,5%.
68. Иммунитет
• Постинфекционныйиммунитет
при
генерализованных формах инфекции стойкий,
напряженный.
• АТ к различным АГ клетки (полисахаридам и
белкам). Полисахаридные АГ сероваров А и С
обладают
высокой
иммуногенностью,
полисахариды сероваров В почти неимуногенны.
• АТ от иммунизированной матери могут
передаваться плоду трансплацентарным путем и
обнаруживаются в течение 2-5 мес. после
рождения ребенка.
69. Микробиологическая диагностика
Материал: кровь, СМЖ,носоглоточные смывы.
1. + микроскопия осадка
центрифугированной
СМЖ и мазков из зева;
при менингококцемии –
микроскопия толстой
капли крови.
70. Микробиологическая диагностика
2.3.
4.
5.
+ Посев на шоколадный агар,
на агар с ристомицином (или
линкомицином), на среду
Мартена
–
агар
с
антибиотиками
(ВКН
–
ванкомицин,
колистин,
нистатин).
Идентификация:
морфология,
Г
«–»,
оксидаза+, серовар. Экспрессдиагностика: определение АГ
в СМЖ и ПЦР.
–
+ РНГА, ИФА.
– Ответ ВТ.
71. Лечение и профилактика
• Антибиотики (пенициллины, левомицетин, рифампицин).• Специфическая
профилактика:
менингококковая
химическая полисахаридная вакцина по эпидемическим
показаниям
при
эпидемическом
подъеме
заболеваемости, в очагах менингококковой инфекции, в
группах населения повышенного риска (дети старше 5 лет
в организованных коллективах, студенты первых курсов
средних и высших учебных заведений, заключенные и
др.).
• Иммуноглобулин человека нормальный вводят детям в
возрасте от 6 мес до 7 лет не позднее 7 суток после
контакта с больным генерализованной формой
менингококковой инфекции.
72. Возбудитель гонореи Neisseria gonorrhoeae
• Гонорея – инфекционнаявенерическая
болезнь,
вызываемая гонококками,
характеризуется гнойным
воспалением слизистых
оболочек,
чаще
мочеполовой системы.
73. Морфология
• Гонококк – Г «–»диплококк
бобовидной формы,
неподвижен; спор не
образует, в организме
образует
нежную
капсулу, имеет пили.
74. Культивирование
• Гонококк – аэроб, требователен к питательнымсредам.
• Применяют
сывороточный,
асцитический,
кровяной или шоколадный агары.
• На асцит-агаре образуют прозрачные колонии с
ровными краями.
• Оптимальные условия для культивирования:
370С, повышенная концентрация СО2 (5-10%) в
атмосфере.
75. Ферментативные свойства
• Ферментирует только глюкозу, образуеткаталазу и цитохромоксидазу.
76. Патогенность
• Пили: адгезия, передвижение по слизистой,образование биопленки.
• Эндотоксин – ЛПС клеточной стенки.
• Капсулярные полисахариды подавляют фагоцитоз.
Характерной особенностью гонококков является их
способность проникать в лейкоциты и размножаться в
них.
77. Патогенез
• Источник инфекции – больной человек.• Механизм передачи – контактный, пути –
половой (гонорея) и прямой контакт
(бленорея). Редко – непрямой контакт (постельное белье, полотенце,
мочалка).
• Входные ворота – слизистая половых органов, прямой кишки, зева,
конъюнктива глаза.
• Чаще – локальная инфекция (уретрит, цервицит, поражение шейки
матки, придатков у мужчин семенных пузырьков, престательной
железы; при экстрагенитальной локализации – повреждение прямой
кишки, миндалин, бленорея новорожденных), у лиц со сниженной
резистентностью –
генерализация процесса (артрит, эндокардит,
менингит).
• Наиболее поражаемые органы – слизистая, подслизистая мочеполовых
путей, конъюнктива, селезенка, костный мозг, печень, суставы (при
генерализации).
• Бессимптомное течение (у женщин – в 60-80%).
• Пути выведения – гнойное отделяемое.
78. Иммунитет
• Иммунитет не формируется (высокая изменчивость,низкая иммуногенность ЛПС).
• Организм борется за счет опсонофагоцитарной реакции и
бактерицидной системы сыворотки крови.
• В крови появляются АТ, но они не обладают
протективными свойствами.
• IgA подавляют прикрепление пилей возбудителя к
клеткам слизистой уретры, но не могут защитить
слизистую от последующего заражения новыми
генерациями гонококков с измененной антигенной
структурой → реинфекция, рецидивы, хронизация.
79. Микробиологическая диагностика
1. + основной: бактериоскопия препаратовгнойного отделяемого, окрашенного по Граму
или метиленовым синим.
2. + при отсутствии результатов микроскопии,
особенно при женской гонореи. РИФ и ПЦР.
3. –
4. + при хронической форме.
5. – ВТ-ответ.
80. Лечение и профилактика
• Лечение – антибиотикотерапия (β-лактамы: цефтриаксон,ципрофлоксацин).
• Специфическая профилактика не разработана.
• Экстренная профилактика: местное применение 0,05% раствора
биглюконата
хлоргексидина;
мерой
предупреждения
инфицирования является использование презерватива. Для
предупреждения бленореи всем новорожденным на конъюнктиву
глаза закапывают раствор антибиотика.
• Вакцина
гонококковая
предназначен
для
диагностики
(установлении
излеченности)
гонореи
и
в
качестве
вспомогательного метода лечения гонорейной инфекции наряду с
другими средствами терапии (больным после безуспешной
антибиотикотерапии, при вяло протекающих рецидивах, при
хронических формах, мужчинам с осложненной и женщинам с
восходящей гонореей, в гинекологической практике при лечении
воспалительных процессов).
81. Клебсиеллы
82. Классификация
КЛАССИФИКАЦИЯ5 группа по Берджи – факультативно-анаэробные Грампалочки
Семейство: Enterobacteriaceae
Род: Klebsiella
Виды:
K. oxytoca
K. planticola
K. terrigena
K. pneumoniae:
Подвиды:
K. pneumoniae
K. rhinoscleromatis
K. ozenae
83. Морфологические и тинкториальные свойства
• Толстые короткие палочки с закругленнымиконцами
• Располагаются попарно или поодиночке
• Грамотрицательные
• Спор не образуют
• Неподвижны
• Имеют выраженную капсулу
84. Культуральные свойства
• Факультативные анаэробы• Хорошо растут на простых питательных средах
• Колонии
на
агаре
круглые,
пышные,
часто
сливающиеся друг с другом, мутные, слизистые
• Рост на бульоне в виде диффузного помутнения
(иногда – со слизистой плёнкой на поверхности)
• Температурный оптимум для роста +37°С (мезофилы),
оптимальная рН 7,2 – 7,4
85. Слизистые колонии клебсиелл
86. Антигенные свойства
•О-АГ – 11 сероваров•К-АГ – 82 серовара
• Желатин не разжижают
• НЕ образуют индол и H2S
87. Заболевания, вызываемые клебсиеллами
Первоначально K. pneumoniae была определена, как микроорганизмвызывающий пневмонию (отсюда и ее название). Однако её роль не
сводится только к инфекциям респираторной системы.
K. pneumoniae классифицируется как условно-патогенный микроб,
находящийся в норме и в определенных органах (например, в
кишечнике) в симбиотическом отношении с человеческим
организмом, а в иных ситуациях являющийся причиной
инфекционных заболеваний.
K. pneumoniae — один из возбудителей внутрибольничных инфекций,
чаще всего мочевыводящих путей, мозговых оболочек, суставов,
могут вызывать сепсис и гнойные послеоперационные осложнения.
В молочных продуктах клебсиеллы могут размножаться даже при
хранении
в
холодильнике
и
могут
вызывать
пищевые
токсикоинфекции.
K. ozaenae вызывает озену - хронический атрофический ринит
(зловонный насморк).
K. rhinoscleromatis вызывает риносклерому - хроническое
гранулематозное заболевание дыхательных путей, поражает глотку,
гортань, трахею.
88. Факторы патогенности клебсиелл
• Факторы адгезии и колонизации:– пили
– белки наружной мембраны
– полисахариды капсулы
• Защита клебсиелл от фагоцитоза (агрессины)
– полисахариды капсулы – К-АГ
• Эндотоксин
ЛПС
• Экзотоксин
энтеротоксин стимулирует активность аденилатциклазы и
отвечает за развитие диареи
89.
Эпидемиология клебсиеллёзных инфекций• Источник
при внутрибольничных инфекциях – человек
больной или бактерионоситель. Может быть
экзо- и эндогенное заражение
• Пути передачи:
1. воздушно-капельный
2. алиментарный (пищевой)
3. контактный
• Восприимчивый коллектив
– любой человек. При внутрибольничных
инфекциях
–
человек
со
сниженным
иммунитетом
90. Микробиологическая диагностика
Исследуемый материал: зависит от клиники илокализации:
мокрота,
слизь
испражнения,
моча,
ликвор,
из
носа,
гнойное
отделяемое, кровь и т.д.
Методы диагностики:
1. Микроскопический (Бактериоскопический)
2. Бактериологический
3. Серологический
91. 1. Микроскопический метод (окраска по Бурри-Гинсу)
92.
2. Бактериологический метод - основнойПосев производят на:
1.дифференциально-диагностическую
среду К-2 (с мочевиной, рафинозой и
бромтимоловым синим)
Колонии
K.
pneumoniae,
выделяющей уреазу и расщепляющей
мочевину, - голубые, а клебсиелл, не
имеющих уреазы, - желтые.
2.
дифференциально-диагностическую
среду с лактозой и бромтимоловым
синим
Колонии сочные и блестящие, цвет
колоний клебсиелл, не расщепляющих
лактозу,
голубой,
а
лактозопозитивные
колонии
K.
pneumoniae желтого цвета.
93.
2. Бактериологический метод - основнойПосев производят на:
3. среду Эндо – лактозонегативные
колонии
–
бесцветные,
лактозопозитивные
–
красные
с
металлическим блеском.
Из подозрительных колоний делают
мазки, окрашивают их по Граму и БуриГинсу и пересевают на скошенный агар
или среду Ресселя для получения
чистой культуры.
Идентификацию
чистой
культуры
проводят по:
1. Биохимическим свойствам
2. Антигенным свойствам:
используют
РА
с
агглютинирующими К-сыворотками
94. Лактозопозитивные колонии на среде Эндо
95.
Биохимические свойства96. 3. Серологический метод
1. РСКс
О-антигеном
химическим
клебсиелл
(с
склеромным
диагностикумом)
2. РА с бактериальным диагностикумом
Диагностически
значимо
четырехкратное увеличение титра АТ в
динамике
97. Специфическое лечение
Бактериофагклебсиеллёзный
поливалетный
Пиобактериофаг
98. Протей
МОРФОЛОГИЯ• (лат.
proteus)
—
род
грамотрицательных,
споронеобразующих, факультативно
анаэробных бактерий. Представитель
нормальной,
условно-патогенной
микрофлоры кишечника человека.
99. СИСТЕМАТИКА
• Род протей (proteus)• семейство энтеробактерии
(enterobacteriaceae),
• порядок энтеробактерии
(enterobacteriales),
• класс гамма-протеобактерии
• (γ proteobacteria),
• тип протеобактерии
(proteobacteria),
• царство бактерии.
100.
proteushauseri
proteus
myxofaciens
Род протей
(proteus)
proteus
mirabilis
proteus
vulgaris
proteus
penneri
101. Свойства бактерий рода Proteus
Мелкие,прямые, нитевидные палочки
размером 1-3хО,4-0,8 мкм.
Очень подвижны (перитрихи, подвижность
более выражена при 20-22 С)
грамотрицательные
Спор и капсул не образуют.
Имеют жгутики, пили, микрокапсулу.
Хемоорганотрофы,
обладающие
окислительным и бродильным типами
метаболизма.
Относительно
устойчивы
к
различным
повреждающим факторам, в т. ч. ко многим
антибиотикам.
102. Биохимические признаки бактерий рода Proteus
ВидФерментация
Образование
Разжи
жение
жела
тина
Глюкоза
Маль
тоза
Ман
нит
Кси
лоза
Сали
цин
Ин
дол
Н2S
Уре
аза
Орнитиндекрбо
ксилаза
P.vulgaris
+
+
-
в
в
+
+
+
-
+
P.mirabili
s
+
-
-
+
в
-
+
+
+
+
P.Penneri
+
-
-
-
-
+
-
+
+
-
Обозначения: «+» - положительная реакция
«-» - отрицательная реакция
«в» - вариабельная реакция
103. Культуральные свойства
•Протеирастут
на
простых
питательных средах,
•t опт=35-37 "С, оптимум рН 7,2-7,4.
•Рост
протей
сопровождается
появлением гнилостного запаха.
•На твёрдых средах жгутиковые (Н-)
формы характеризуются сплошным
ростом.
104. Культуральные свойства
1. Насреде
Плоскирева
протеи
формируют
желтовато-розовые
колонии.
2. На висмут-сульфитном агаре через
48 ч образуют серо-коричневые
колонии (с чёрно-коричневой зоной
под ними).
3. На агаре Эндо протеи формируют
бесцветные колонии. Вызывают
помутнение
жидких
питательных
сред.
105. Культуральные свойства
•При посеве бляшкой бактерии даютфеномен «роения» — образуют
концентрически расходящиеся зоны
роста голубовато-серого цвета
(P. Vulgaris, P. Mirabilis).
106. Антигены протей
О-антигены(49
сероваров)
Н-антигены
(19
сероваров)
О-антигены с
риккетсиями
(OX-19, OX-2, OX1K).
107. Факторы патогенности
• Фимбриивызывают
агглютинацию
эритроцитов животных и человека.
• Протеи разлагают мочевину, используя её в
качестве источника энергии, причём
конечные продукты метаболизма (хлорид
аммония) вызывают местное воспаление и
повышают
рН
до
значений,
способствующих образованию кристаллов
(струвитов), камней и застою мочи.
108. Факторы патогенности
• Гемолизиныразрушают
эритроциты,
нейтрофилы и фибропласты человека.
• Протеазы нарушают структуру различных
подклассов
IgA
и
IgG,
повышают
проницаемость сосудов, дезаминируют
аминокислоты
и
действуют
как
сидерофоры.
109. ПАТОГЕНЕЗ
• Протей — причина заболеваний человека• Острые кишечные инфекции,
• у детей раннего возраста,
• Гнойно-воспалительные заболевания
• мочевыводящей системы,
• (при осложнениях калькулёзного пиелонефрита)
• При пищевой токсоинфекции,
Вторичные септические поражения у пациентов
с ожогами и после хирургических вмешательств.
• Proteus mirabilis – причина раневых инфекций.
110. Экология и эпидемиология
•P.Vulgarisи P.mirabilis –условно-патогенные
бактерии, обитатели кишечника человека и животных.
•Они обнаруживаются в сточных водах, почве, куда
попадают с испражнениями.
•Источник инфекции- люди, животные.
•Пути заражения- контактный, оральный.
Протеи - санитарно-показательные бактерии.
Кол-во proteus mirabilis – показатель
фекального загрязнения,
Кол-во proteus vulgaris — показатель
загрязнения
объекта
органическими
веществами.
111. ЛАБОРАТОРНАЯ ДИАГНОСТИКА
112. ЛАБОРАТОРНАЯ ДИАГНОСТИКА
• Идентификация бактерий рода Proteus—самая несложная во всём семействе
Enterobacteriaceae. Их легко распознают по
способности давать феномен «роения».
• Важнейший признак протей, отличающий
протей от прочих энтеробактерий, —
способность дезаминировать фенилаланин.
113. Чистая культура P.vulgaris Окраска по Грамму
114. Лечение протейной инфекции
• Препараты выбора при лечении протейнойинфекции:
ампициллин,
цефалоспорины третьего поколения,
фторхинолоны.
• При дисбактериозах кишечника можно
назначать интестибактериофаг (смесь
фагов, включающая протейный фаг) внутрь.
115. Лечение протейной инфекции
• Протейныйбактериофаг (коли-протейный фаг)
также применяют местно (при гнойных процессах
или поражениях мочеполовой системы).
При избыточном росте протея (proteus mirabilis,
proteus vulgaris) детям рекомендованы
бактериофаги
«Интести-бактериофаг жидкий»,
«Бактериофаг протейный жидкий»,
«Бактериофаг колипротейный жидкий»,
«Колипротеофаг в таблетках»,
«Пиобактериофаг комбинированный жидкий»,
«Пиополифаг в таблетках»,
«Пиобактериофаг поливалентный очищенный
жидкий».
116. Псевдомонады
Синегнойная палочкаТаксономическое положение
Семейство Pseudomonadaceae
род Pseudomonas, включает свыше 20
видов
Патогенные виды:
P.Aeruginosa,
P.mallei,
P.pseudomallei
117. Морфология
Гр- палочки, имеют прямуюили слегка изогнутую форму
Не образуют споры, имеют 1-2
полярных жгутика и
капсулоподобную оболочку.
Большинство штаммов
образуют растворимый
пигмент пиоцианин (синезеленый в щелочной среде)
Капсула синегнойной палочки
118. Синегнойная палочка
119. Биохимическая активность
• Хорошовыражена
протеолитическая
активность,
слабо
выражена
сахаролитическая.
• Относится
к
неферментирующим
бактериям вместе с Acinetobacter baumannii
• Продуцирует бактериоцины – пиоцины
(белки, оказывают бактерицидный эффект
на микроорганизмы аналогичного или
генетически близкого вида).
120. Культуральные свойства
Строгие аэробы, оксидоположительны,Растет в широком диапазоне температур (442°С) –
факультативные психрофилы
Не требовательны к питательным средам
Растёт на МПА (среда окрашивается в синезелёный цвет), МПБ (в среде помутнение и
пленка, также сине-зелёный цвет, селективная
среда — ЦПX-агар (питательный агар с
цетилпиридиний-хлоридом)
Колонии и питательная среда окрашены в синезеленый цвет вследствие выработки
синегнойной палочкой пигмента пиоцианина.
Пигмент пиовердин предназначен для
связывания ионов железа
121. Пиоцианин
• Инактивирует каталазу• Модулирует глутатион – важный
антиоксидант
• В легких превращает кислород в
супероксидный радикал, окисляя
NADPH в NADP+.
• Подавляет продукцию лейкоцитами
активных форм килорода (reactive
oxygen species (ROS)
• Мишенью в клетке могут быть
различные компоненты и пути,
включая дыхательную цепь,
везикулярный транспорт и рост
клетки
122. Факторы патогенности
Вирулентность: обеспечивается
гликопротеидной капсулоподобной
оболочкой, пилями, белками
наружной мембраны клеточной стенки
• Токсины:
– Экзотоксин А (термолабильный
белок, отвечает за инвазивные
свойства, угнетает иммуногенез.
Механизм действия – блокирует
синтез белка)
– Мембранотоксины (гемолизин I
типа – способствует
возникновению очагов некроза и
гемолизин II типа – усиливает
действие гемолизина I типа)
– Лейкоцидин – лизирует лейкоциты, выделяется только при аутолизе
• Факторы инвазии: нейроминидаза, протеазы
123. Факторы патогенности
P.Aeruginosa образует биопленкина поверхности слизистых
Факторы патогенности P.aeruginosa
Экзотоксин А – АДФ-рибозилирование
фактора элонгации 2 - цитотоксин
124. Факторы патогенности
ExoA - AB токсин, блокирует синтез белкаExoS - вводится в клетку хозяина системой секреции
тип III, вызывает внутриклеточную дисфункцию за
счет повреждения цитоскелета
Эластаза – секретируется во внеклеточное
пространство ; разрушает С5а (препятствует
опсонизации), тесные связи между клетками, белки
сурфактанта
Совместное действие трех факторов разрушает
клетку и ведет к бактериемии
125.
126. Особенности патогенеза инфекций, вызванных P.aeruginosa
• Широко распространена вовнешней среде, что способствует
легкому инфицированию.
• Иммунитет неспецифический
• Длительное время сохраняется на
предметах обихода, плохо
простерилизованных медицинских
инструментах, особенно в раневом
отделении
• Заражение в основном контактным
путем
• Относится к внутрибольничным
инфекциям
127. Эпидемиология
• P.аeruginosa распространена повсеместно вприроде, почве, воде, растениях, животных
(включая человека)
cапроноз
• Большое значение в циркуляции P.аeruginosa имеет вода, в
которой он может сохраняться до 1 года при температуре 37°С, в
том числе во многих растворах, применяемых в медицине
(например, жидкость для хранения контактных линз).
• Иногда входит в состав нормальной микрофлоры (кожа паха,
подмышечной области, ушей, носа, глотки, ЖКТ).
• P.аeruginosa вызывает до 10-20% всех внутрибольничных
инфекций, вызывая такие инфекции как пневмония, инфекции
мочеполовой системы и бактериемию. Наиболее часто
высевается у больных, находившихся более 7 дней в стационаре.
128. Лабораторная диагностика инфекций, вызываемых Pseudomonas aeruginosa
Клинические образцы: гной, мокрота,
кровь, моча, спинномозговая жидкость, и
т.д.
Методы:
1. Бактериологических метод: главный
метод
2. Серологический метод.
129. Бактериологический метод
1 этап: Посев клинических образцов (гноя, мокроты, и т.д.) напитательный, кровяной или селективный агар.
2 этап: Изучение культуральных свойств колоний по методу Грама. В
большинстве
случаев
диагностика
очевидна
благодаря
образованию пиоцианина. Посев изолированной колонии на
скошенный агар.
3 этап: Идентификация свойства окраски (мазок, окрашенный по
методу Грама); культуральные свойства; биохимические свойства,
определенные по дифференциальной-диагностической системе
API-20E; факторы вирулентности; серологическая идентификация;
определение устойчивости к антибиотикам.
130. Синегнойная палочка
Тест на цитохромоксидазу.Наличие фермента приводит к образованию синефиолетового окрашивания тест-полоски
131. Рана, зараженная Pseudomonas aeruginosa (до и после лечения)
132. Принципы лечения инфекций, вызванных Pseudomonas aeruginosa
1. Антибиотики (устойчивость должна быть точновыявлена диско-диффузным методом);
2.
Анти-псевдомонадные
бактериофаги(для
локальных инфекций),пиобактериофаги;
3. Анти-псевдомонадные анатоксины(особенно для
лечения хронических инфекций);
4. Гипериммунизированная анти-псевдомонадная
плазма,
сыворотка,
иммуноглобулин
(для
излечения токсинемии, вызываемой P. aeruginosa );
5.
Анти-псевдомонадная
вакцина
или
комбинированный
вакцины,
содержащие
антигены для
P.aeruginosa
(для
лечения
хронических
заболеваний).
133. Антибиотки, действующие против P. aeruginosa включают:
• аминогликозиды (гентамицин, амикоцин, томбромицин);• хинолоны
(ципрофлоксацин,
левофлоксацин,
имоксифлоксацин)
• цефалоспорины
(цефтазидим,
цефипим,
цефоперазон,
цефпиром, но не цефуроксим, цефтриаксон, цефотаксим)
• полимиксины (полимиксин B и колистин)
• Монобактамы (азтреонам)
Микроорганизм
P.aeruginosa
Препараты выбора
монотерапия
комбинации
Цефтазидим
Цефепим
Ципрофлоксацин
Цефтазидим +
аминогликозиды
Цефепим +
аминогликозиды
Ципрофлоксацин +
аминогликозиды
Альтернативные
препараты
Антисинегнойные
пенициллины
(за исключением ОРИТ),
азтреонам или
карбапенемы +
аминогликозиды
134. НЕСПОРООБРАЗУЮЩИЕ АНАЭРОБЫ
• НЕСПОРООБРАЗУЮЩИЕАНАЭРОБЫ
–
это
грамотрицательные
(бактеройды,
фузобактерии,
вейлонеллы
и
др.)
или
грамположительные
(актиномицеты,
пептококки,
пептострептококки)
бактерии палочковидной или кокковидной формы с
разнообразным биологическими свойствами.
135. НЕСПОРООБРАЗУЮЩИЕ АНАЭРОБЫ морфология и биология
• Разнообразна в связи с многочисленностью видов. Имиобильно засеяны слизистые оболочки ротовой полости,
толстой кишки, мочеполового тракта.
• Культивирование осуществляется в микроанаэростатах в
отсутствии кислорода и в присутствии смеси N₂, СО₂, Н₂.
136. НЕСПОРООБРАЗУЮЩИЕ АНАЭРОБЫ эпидемиология и клиническая картина
• Являются основной частью нормальной микрофлорыорганизма человека. Они вызывают заболевания при
снижении напряженности иммунитета.
Являются
причиной гнойно-воспалительных процессов в челюстнолицевой области, легких, печени, мочеполовой системе.
Они могут вызвать аппендицит, перитонит, сепсис, абцесс
мозга.
137. НЕСПОРООБРАЗУЮЩИЕ АНАЭРОБЫ микробиологическая диагностика
• Бактериологическое исследование – выделение чистойкультуры и ее идентификация.
• Экспресс-анализ – применяют источник коротковолновой
части видимого спектра с длинной волны 400-420 нм при
запирающих фильтрах с границей пропускания более 500
нм. При наличии анаэробов в гнойном содержимом
наблюдают малиново-красное свечение.
138. НЕСПОРООБРАЗУЮЩИЕ АНАЭРОБЫ лечение и профилактика
Лечение – используют антибиотики, широкого спектрапрофиля: метронидазол, клиндамицин, цефалоспорины,
левомицитин, эритромицин.
Специфическая профилактика – неразработана из-за
разнообразия возбудителя.
Неспецифическая профилактика – меры асептики и
антисептики в больнице.
139. Дрожжеподобные грибы
140. КЛАССИФИКАЦИЯ ГРИБОВ
Надцарство – ЭукариотыЦарство - Грибы (Mycota или Fungi)
Отделы - Грибы-слизевики (Myxomycota)
Настоящие грибы (Eumycota)
Классы - низшие грибы
грибы
Chitridiomycetes
Ascomycetes
Hyphochitridiomycetes
Oomycetes
Zygomycetes
высшие
Basidiomycetes
Deuteromycetes
141. 2 типа морфологии грибов
гифальныйдрожжевой
142. Классификация микозов
1 группа – системные(глубокие) микозы
2 группа – подкожные микозы
3 группа – микозы кожи и ее
придатков
(дерматомикозы)
4 группа – поверхностные
микозы
143. Оппортунистические микозы
МукорозАспергиллез
Пенициллиноз
Кандидоз
144. Дрожжи
145. Candida
146. ФАКТОРЫ РИСКА ОППОРТУНИСТИЧЕСКИХ МИКОЗОВ
ФИЗИОЛОГИЧЕСКИЕ СОСТОЯНИЯМЕСТНЫЕ НАРУШЕНИЯ
ИММУННЫЕ НАРУШЕНИЯ
ЯТРОГЕННЫЕ
ПРОФЕССИОНАЛЬНЫЕ
147.
Возбудители кандидозаКласс
Род
Deuteromycetes
Candida
Виды
C.albicans
C.tropicalis
C.glabrata
C.parapsilosis
C.krusei
148. Характеристика грибов Candida
ВидC.albicans
C.tropicalis
C.kefyr
C.krusei
Рост на
Рост на
твердых средах
жидких средах
Колонии
Осадок, иногда небольшое
сметанообразные (белые пристеночное кольцо
или кремовые),
выпуклые, круглые
Колонии двухзональные, Поверхностная пленка,
Псевдомицелий
первые 2 суток
высокое пристеночное кольцо сильно развит, много
сметанообразные, затем
бластоспор и
мозговидные, края
псевдоконидий
сглаженные, изрезанные
Колонии плоские,
сероватые, влажные
Осадок, среда прозрачная
Колонии сухие, матовые, Поверхностная пленка,
серые, плоские, с мелкой нежное сползающее высокое
зернистостью в центре
пристеночное кольцо
C.guilliermondii Колонии низкие, белые,
блестящие
C.parapsilosis
Филаментация на
Наличие
картофельном агаре хламидоспор
Псевдомицелий
ветвистый, в толще
+
среды древовидный
Колонии гладкие,
влажные,
сметанообразные
Осадок, среда прозрачная
Псевдомицелий
тонкий, бластоспор
мало
Псевдомицелий
развитый
Псевдомицелий
тонкий, бластоспоры
мелкие
Низкое пристеночное кольцо, Псевдомицелий развит
осадок
слабо
_
_
_
_
_
149. C. albicans электронная микроскопия
150. Бластоспоры C. albicans
151. Псевдомицелий
152.
Дрожжеподобная и гифальная формаC.albicans
153.
C.albicans: псевдомицелиймакроскопически в колониях
154.
C.albicans: псевдомицелий155.
C.albicans: хламидоспоры156.
C.albicans: ростовая трубка157.
158.
C.albicans: колонии на средеСабуро
159.
Колонии на хромогенных средахДля выделения и дифференциации
Candida spp.
160.
Колонии кандиды161. Ферментативные свойства некоторых видов Candida
Углеводылактоза сахароза мальтоза
К (КГ)
КГ
Виды
C.albicans
глюкоза
КГ
C.tropicalis
КГ
-
КГ
КГ
C.pseudotropicalis
КГ
КГ
КГ
-
C.krusei
КГ, К
-
-
-
C.parapsilosis
КГ, К
-
-
-
C.guilliermondii
КГ
-
КГ
-
162. Механизмы защиты
Неспецифические-кожа, слизистые (неповрежденная,
шелушение, слущивание, вымывающее
действие, ферменты: лактоферрин
-нормальная микрофлора
-комплемент (альтернативный путь)
-NK
163. Специфические Гуморальные: -sIg A -сывороточные Ig G,М,А Клеточные: -фагоцитоз: ПЯЛ, макрофаги -СД8 Т лимфоциты -СД4 Т
лимфоциты 1 типа: увеличение цитокинов:ИЛ-2, интерферон-гамма,
колониестимулирующий фактор
Аллергизация : ГЗТ
164.
Факторы патогенности•Адгезия: фимбрии,
поверхностные
гликопротеины
•Инвазивность - способность
образовывать гифальную
форму (проникновение в
клетку, до ядер)
165.
Факторы патогенности•Ферменты:
кератинолитические
протеолитические
фосфолипаза
•Меланин (защита от окисления и УФЛ)
•Капсула (C.neoformans)
•Иммуносупрессивное действие
(маннан клеточной стенки)
•Высокая адаптационная
способность
•Эндотоксин
•Лекарственная устойчивость
166. Клиническая классификация кандидоза
I.II.
Поверхностный кандидоз
Кандидоз кожных складок
Кандидоз гладкой кожи
Кандидозная паронихия и онихия
Кандидоз полости рта в форме стоматита,
заеды, хейлита
Кандидозный вульвовагинит
Кандидозный баланит и баланопостит
167.
ФАКТОРЫ РИСКА РАЗВИТИЯКАНДИДОЗНОГО ВУЛЬВОВАГИНИТА
ФИЗИОЛОГИЧЕСКИЕ:
беременность
менструация
ЭНДОКРИННЫЕ:
сахарный диабет
гипотиреоз
ИММУНОДЕФИЦИТ:
патология, связанная с
иммунодефицитом
КАНДИДОЗНЫЙ ВУЛЬВОВАГИНИТ
МЕХАНИЧЕСКИЕ:
синтетическое белье
первый половой
контакт
травматические
повреждения тканей
влагалища
ВМС (длительное
ношение
ЯТРОГЕННЫЕ:
антибиотики
кортикостероиды
иммуносупрессоры
химиотерапия онкологических заболеваний
лучевая терапия
оральные контрацептивы
ПРОЧИЕ:
аллергические
заболевания
гиповитаминоз
хронические
заболевания гениталий
хронические
заболевания ЖКТ
168.
II. Хронический генерализованный(гранулематозный) кандидоз
III. Висцеральный кандидоз различных органов
а) пищеварительный тракт
б) органы дыхания
в) мочеполовая система
в) кандидозная септикопиемия
г) кандидозный хрониосепсис
е) внутриутробный (врожденный)
генерализованный кандидоз
новорожденных.
169.
Методы лабораторной диагностикиМикроскопический
Микологический
Серологический
Кожно-аллергическая проба
170.
Определение чувствительности кфлуконазолу
171. Противогрибковые препараты
Фунгицидные:-подавление синтеза ДНК: флуцитозин
-повреждение цитомембраны – полиены:
амфотерицин В, нистатин
Фунгистатические:
азолы - подавление синтеза стерола:
имидазол, флюконазол, клотримазол
172. Препараты, применяемые для лечения кандидоза.
173.
174.
В зависимости от состояния вагинального микроценоза выделяют3 формы кандидозной инфекции влагалища:
1. Бессимптомное кандидоносительство –
отсутствуют клинические проявления заболевания,
Candida выявляются в низком титре (менее 104 КОЕ/мл),
доминируют лактобациллы в умеренно большом количестве.
2. Истинный кандидоз –
выраженная картина вагинального кандидоза,
Candida в титре более 104 КОЕ/мл,
высокий титр лактобацилл (более 106 КОЕ/мл),
отсутствие диагностически значимых титров других условнопатогенных микроорганизмов.
3. Сочетание вагинального кандидоза и бактериального
вагиноза –
Candida в высоком титре,
облигатные анаэробные бактерии и гарднереллы в титре
более 109 КОЕ/мл,

medicine
medicine








